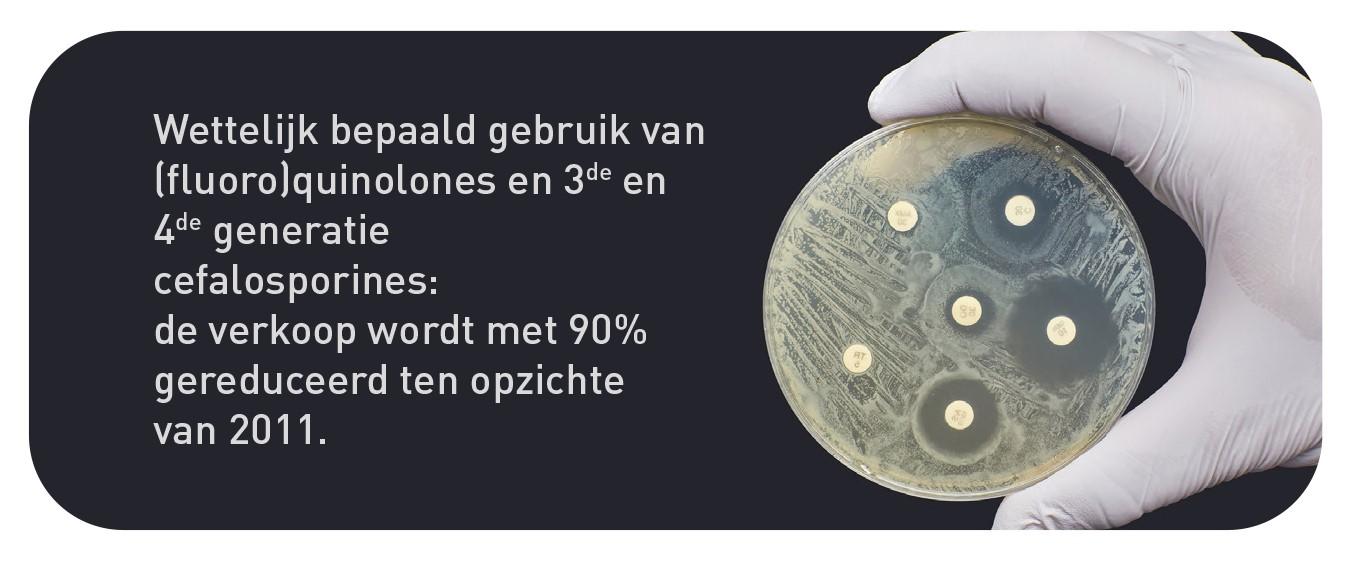

Vijf doelstellingen





Negen actiepunten
Om deze doelstellingen te kunnen behalen, werden ook 9 actiepunten vastgelegd in AMCRA visie 2030.

Om deze doelstellingen te kunnen behalen, werden ook 9 actiepunten vastgelegd in AMCRA visie 2030.